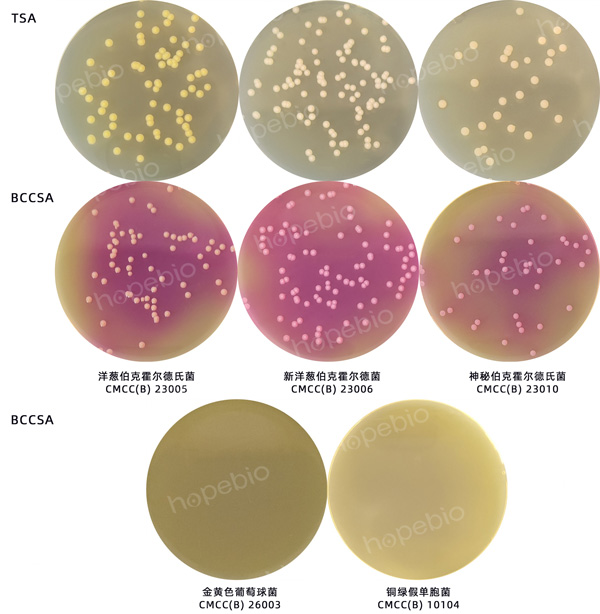

海博微信公众号
海博微信公众号
 海博天猫旗舰店
海博天猫旗舰店


 海博微信公众号
海博微信公众号
 海博天猫旗舰店
海博天猫旗舰店




一、产品介绍
用途:本培养基用于药品中洋葱伯克霍尔德菌的选择性分离培养。
添加剂:每瓶需配套添加6盒HB9240a BCCSA抑菌剂(1支含庆大霉素2mg,万古霉素0.5mg,多粘菌素B 120000U)使用。
原理:胰蛋白胨和酵母提取物为微生物的生长提供氮源、维生素及生长因子;蔗糖提供碳源;结晶紫可以抑制革兰氏阳性菌;丙酮酸钠促进微生物的生长;磷酸二氢钾维持pH稳定;氯化钠维持渗透压;酚红为酸碱指示剂,变色范围pH:6.8(黄)-8.4(红);琼脂为凝固剂;抑菌剂可抑制革兰氏阳性菌及大部分革兰氏阴性菌的生长。
二、培养基配方(g/L)
|
胰蛋白胨 |
10.0 |
|
酵母提取物 |
1.5 |
|
蔗糖 |
2.0 |
|
结晶紫 |
0.001 |
|
丙酮酸钠 |
7.0 |
|
磷酸二氢钾 |
1.54 |
|
氯化钠 |
5.0 |
|
酚红 |
0.02 |
|
琼脂 |
14.0 |
|
pH值6.2±0.2(25℃) |
|
三、试验方法
1、称取本品41.06g,加热煮沸溶解于1000mL纯化水中,分装三角瓶,121℃高压灭菌15min,冷却至45℃-50℃时,每200mL培养基中加入1支BCCSA抑菌剂,混合均匀,倾入无菌平皿,备用。
2、制备质控菌液接种到洋葱伯克霍尔德菌群选择性琼脂培养基及参比培养基TSA上。
3、放置于30℃-35℃需氧培养48h-72h。
四、结果观察
接种以下质控菌株,放置于30℃-35℃需氧培养48h-72h。培养结果如图1。
|
质控菌株 |
菌株编号 |
接种量(CFU) |
参比培养基 |
方法 |
质控结果 |
其他特征 |
|
洋葱伯克霍尔德氏菌 |
CMCC(B) 23005 |
10-100 |
TSA |
定量 |
PR≥0.5 |
培养基变红 |
|
新洋葱伯克霍尔德菌 |
CMCC(B) 23006 |
10-100 |
TSA |
定量 |
PR≥0.5 |
培养基变红 |
|
神秘伯克霍尔德氏菌 |
CMCC(B) 23010 |
10-100 |
TSA |
定量 |
PR≥0.5 |
培养基变红 |
|
金黄色葡萄球菌 |
CMCC(B) 26003 |
/ |
/ |
定性 |
/ |
抑制 |
|
铜绿假单胞菌 |
CMCC(B) 10104 |
/ |
/ |
定性 |
/ |
抑制 |
图1 洋葱伯克霍尔德菌群选择性琼脂培养基(BCCSA)的微生物质控结果
相关产品
洋葱伯克霍尔德菌群选择性琼脂培养基(BCCSA)(中国药典)-点击查看产品详情
注:本文属海博生物原创,未经允许不得转载。
下一篇:没有了!
| 相关文章: | ||



